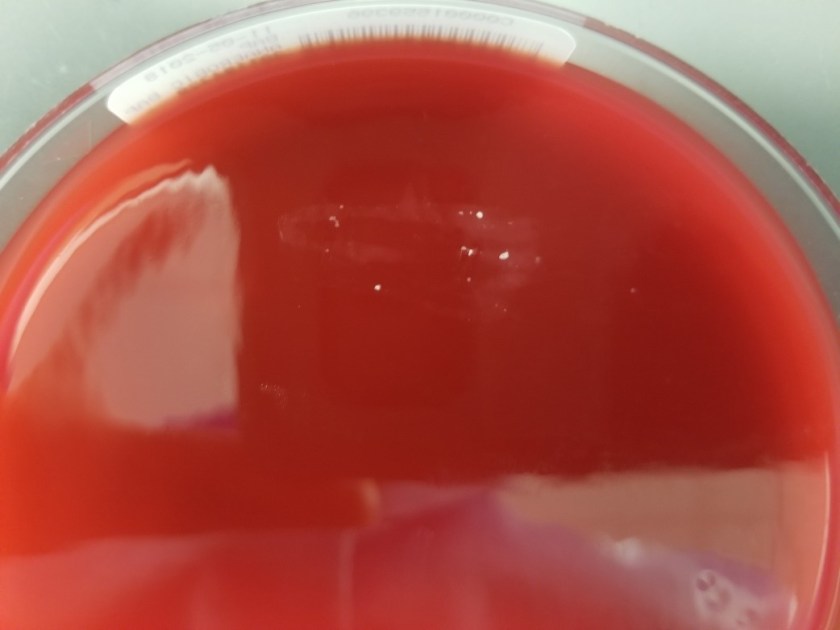
corynekrop1

Case History
Our patient is a 45-year-old female who presents to the Emergency department with breast pain. She was diagnosed with granulomatous mastitis 3 months prior. She was treated with 3 weeks of steroids, but they were stopped when the mass was unchanged and the patient was experiencing increasing breast tenderness. Since then she and has undergone several procedures to drain her right breast abscess, the most recent being five days prior. The woman has been treated with sequential courses of sulfamethoxazole–trimethoprim and metronidazole without improvement. On this visit, the abscess was again drained and sent to the microbiology laboratory for culture. The Gram stain showed no bacteria and 3+ polymorphonuclear cells. After 48 hours incubation there was scant growth on the blood agar plate and no growth on the chocolate, MacConkey or CNA plates. The colonies growing on the blood plate were tiny, white, and lipophilic (Image 1).
Discussion
The organism was identified as Corynebacterium kroppenstedtii.
Colonies on the blood agar plate were identified as Corynebacterium kroppenstedtii using MALDI-TOF mass spectrometry for identification. C. kroppenstedtii is catalase positive, non-motile and a facultative anaerobe. It grows better on 5% sheep blood agar than chocolate agar, as is the case for many Corynebacterium spp. Corynebacterium come in two varieties, lipophilic such as Corynebacterium jeikeium, and luxuriantly growing, such as Corynebacterium straitum. C. kroppenstedtii is part of the former lipophilic group, forming small colonies after extended incubation. Lipids such as Tween-80 can added to the media to improve growth of lipophilic Corynebacterium such as C. kroppenstedtii, but clinically this is not routinely performed. When viewed on a gram stain, the bacteria are rod-shaped gram positive diptheroids with typical coryneform morphology. Both MALDI-TOF and 16S rRNA sequencing can accurately identify C. kroppenstedtii to the species level.
C. kroppenstedtii is a relatively newly recognized species within the Corynebacterium genus. It was first described in a case series of young Polynesian women with histological evidence of lobar mastitis, from which C. kroppenstedtii was identified from >40% of the patients’ abscesses. Since that time, isolation of C. kroppenstedtii has been clinically associated with breast abscesses and granulomatis mastitis. C. kroppenstedtii is a highly lipophilic bacterium. Its cell wall lacks many mycolic acids, which may explain its propensity to grow in lipid-rich sites such as mammary glands. C. kroppenstedtii typically affects women of reproductive age and can be difficult to diagnose due to the slow growing nature of the lipophilic organism and the relatively few organisms present in abscess specimens.
Prior to identification by MALDI-TOF MS and 16s rRNA sequencing this patient’s culture would have been reported as rare or 1+ “dipthroid,” “coryneform,” or “Corynebacterium spp.” Without knowing the clinical significance of this organism, the culture results could easily be dismissed as contaminating skin flora.
It is very difficult to treat C. kroppenstedtii in abscesses, with the most effective treatment requiring both surgical drainage of the abscess and long term antibiotic use. It is fairly difficult to get antibiotics to the site of infection, so antibiotics that test as susceptible in the laboratory may not eradicate the pathogen. Our patient’s isolate of C. kroppenstedtii was susceptible to ciprofloxacin, clindamycin, doxycycline, and intermediate to penicillin. She remains on ciprofloxacin therapy, but has ongoing right breast tenderness. She had another surgical drainage of her breast abscess a week after this case, and the culture also grew 1+ C. kroppenstedtii with 3+ PMN seen on Gram stain, so her infection has not yet been resolved.
References
- Tauch, Andreas, et al. “A Microbiological and Clinical Review on Corynebacterium Kroppenstedtii.” International Journal of Infectious Diseases, vol. 48, 2016, pp. 33–39., doi:10.1016/j.ijid.2016.04.023. ScienceDirect.
- Johnson, Matthew G., et al. “The brief case: recurrent granulomatous mastitis due to Corynebacterium kroppenstedtii.” Journal of clinical microbiology 54.8 (2016): 1938-1941.
- Paviour, Sue, et al. “Corynebacterium species isolated from patients with mastitis.” Clinical Infectious Diseases 35.11 (2002): 1434-1440.

-Carolyn Wiest, MT(ASCP) graduated from Michigan State University with a BS in molecular genetics and is a medical technologist at NorthShore University HealthSystem. Her interests are in microbiology and molecular diagnostics.

-Erin McElvania, PhD, D(ABMM), is the Director of Clinical Microbiology NorthShore University Health System in Evanston, Illinois.
Thanks !! V.nice case….
May I know how coagulase negative staphylococcus if grown in pus samples should be interpreted by you and your team!???
If anyone is doing research and is looking for patients who have Granulomatous Mastitis, there are two private Facebook groups called “Granulomatous Mastitis” and “Idiopathic Granulomatous Mastitis (IGM).” The first group has over 400 members (who have or have had the disease). It’s a terrible thing to endure. I am in the 4th year of the disease and I truly hope that more is done to understand and treat/cure the disease.
Hi Erin, if we said a colony was lipophlic, does it mean that the colony had fat looking or something else?
Cheers, Michael